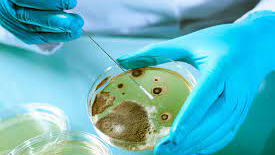
Інформує Лубенський підрозділ ДУ "«Полтавський обласний центр контролю та профілактики хвороб"

У Лубенській міській бібліотеці для дітей відбулося традиційне передноворічне свято. Захід втілився в життя за підтримки директора ГО «СЖТ «За майбутнє дітей України» Раїси Кошель та депутата Полтавської обласної ради Наталії Сухонос. Святкову подію відкрила директор Публічної бібліотеки Валентина Сьомак. А потім фахівці дитячої книгозбірні повели всіх присутніх у святкову круговерть фольклорним вернісажем «Замріяна казка Зими» , який захопив всіх: і дорослих, і малечу.
У зв’язку із проведенням робіт у мережах АТ «ПОЛТАВАОБЛЕНЕРГО» можливі тимчасові перерви в електропостачанні споживачів. Дата, орієнтовний час початку та закінчення перерви вказані у таблиці.
Слава Україні! Розпочалася 1 399-та доба широкомасштабної збройної агресії рф проти України.
Загалом, протягом минулої доби зафіксовано 205 бойових зіткнень. За уточненою інформацією, вчора загарбники завдали по території України 14 авіаційних ударів, скинувши 41 керовану авіаційну бомбу. Крім цього, залучили для ураження 4563 дронів-камікадзе та здійснили 3857 обстрілів позицій наших військ і населених пунктів, зокрема 98 – з реактивних систем залпового вогню.
Наші воїни завдають окупаційним військам відчутних втрат у живій силі й техніці та активно підривають наступальний потенціал ворога в тилу. Загалом, минулої доби втрати російських загарбників склали 1420 осіб. Також українські воїни знешкодили вісім танків, 20 бойових броньованих машин, 23 артилерійських системи, реактивну систему залпового вогню, два літаки (підтверджено втрати у попередній період), 453 безпілотних літальних апарати оперативно-тактичного рівня та 113 одиниць автомобільної техніки окупантів.
Станом на ранок 23 грудня 2025 року ситуація на території Лубенської громади стабільна та контрольована.
Станом на 8 годину ранку триває повітряна тривога. Ворог завдає масованого удару по Україні. Не наражайтеся на небезпеку та обов’язково пройдіть в укриття.
22 грудня під головування Олександра Грицаєнка відбулося чергове засідання виконавчого комітату Лубенської міської ради. Було розглянуто 24 питання порядку денного. Члени виконкому схвалили проєкт рішення «Про бюджет Лубенської міської територіальної громади на 2026 рік». Проєкт представила начальник фінансового управління виконавчого комітету Лубенської міської ради Тамара Романенко.
Рішенням виконкому затверджено вартість харчування учнів закладів загальної середньої та вихованців дошкільної освіти Лубенської територіальної громади на 2026 рік. За інформацією начальника Управління освіти виконавчого комітету Лубенської міської ради Мирослава Костенка середня вартість харчування однієї дитини на день у закладах дошкільної освіти сільських населених пунктів Лубенської територіальної громади з урахуванням режиму роботи та вікових категорій дітей складає: групи віком від одного до трьох років та від трьох до чотирьох років – 61грн. 21коп., зокрема батьківська плата – 36грн. 73коп.; групи віком від чотирьох до шести (семи) років – 86грн. 00коп., зокрема батьківська плата – 51грн. 60коп.; групи з перебуванням дітей 6 год. віком від двох років шести місяців до шести (семи) років – 65грн. 65коп., зокрема батьківська плата – 39грн. 39коп. Батьківська плата складає 60% від вартості харчування на день.
Небезпека пічного опалення обумовлюється тим, що кожна піч - це вогнедіюче джерело. Частіше за усе пожежі відбуваються через перегрівання печей, появи у цегляній кладці тріщин, а також в результаті застосування для розтоплювання печей горючих і легкозаймистих рідин, випаданні з топки або зольника вуглин.
Днями в Лубенській міській бібліотеці для дорослих ім.В.Леонтовича відбувся психологічний тренінг на тему: «Як перестати шкодувати про те, що трапилося», який професійно провела Ірина Морозенко – фахівець супроводу ветеранів війни КП «Лубенська лікарня інтенсивного лікування».
Лубенський районний відокремлений підрозділ Державної установи «Полтавський обласний центр контролю та профілактики хвороб Міністерства охорони здоров’я України» надає інформацію щодо захворюваності на гострі респіраторні інфекції за 51-й тиждень 2025 року.
Напередодні Різдва нашу громаду наповнюють гарні, світлі новини про народження малечі.
За інформацією Управління охорони здоров’я виконавчого комітету Лубенської міської ради з 24.02.2022 р. по 22.12.2025 р. в пологовому відділенні народилося 1044 дітей: 517 дівчаток і 527 хлопчиків, в тому числі за 2025 рік народилося 198 дітей: 108 дівчаток і 90 хлопчиків.
Бажаємо всім новонародженим здоров’я, радості, тепла родинного дому та щасливого дитинства. Хай кожен їхній крок по життю буде сповнений світла, любові та щирих усмішок!
Наш славний Лубенський край – осередок творчості, своєрідний фундамент, на якому зростають талановиті особистості.
До них належить і суботній гість Лубенської міської бібліотеки для дорослих ім. В. Леонтовича - письменник, викладач, логопед, хорист, надзвичайно цікавий співрозмовник Олександр Козинець. «Усі вже знають», що світло його душі переливається і в його твори, які вже склали вагомий творчий доробок на «Полотні роду» автора.
Щороку, 22 грудня, в день зимового сонцестояння, в Україні святкують День енергетика. Це свято символічно припадає на найкоротший день і найдовшу ніч у році, коли робота енергетиків найбільш помітна. Це свято тих, хто не просто виконує свою роботу, а здійснює справжні подвиги.
Вітаємо всіх працівників енергетичної промисловості, що залучені у виробітку, транспортуванні та збуті кінцевим споживачам теплової та електричної енергії.
У зв’язку із проведенням робіт у мережах АТ «ПОЛТАВАОБЛЕНЕРГО» можливі тимчасові перерви в електропостачанні споживачів. Дата, орієнтовний час початку та закінчення перерви вказані у таблиці.

.jpg)

